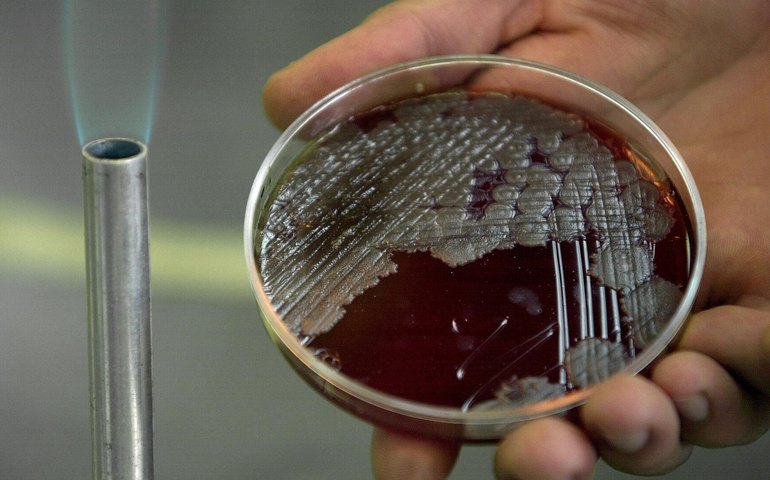

Internacional
Mirando nos russos e livrando os americanos: quais armas biológicas o Pentágono está desenvolvendo?
Os EUA estão conduzindo pesquisas biológicas militares com o objetivo de descobrir novas bactérias e vírus prejudiciais, feitos sob medida para infectar determinadas raças, nacionalidades e mesmo residentes de regiões específicas, afirmou Igor Korotchenko
O Serviço Federal de Segurança da Rússia (FSB) divulgou nesta sexta-feira (27) que o espião americano condenado Eugene Spector havia coletado e transmitido dados biotecnológicos de russos ao Pentágono para ajudar a criar um sistema de triagem genética de alta velocidade.
O objetivo do Pentágono é desenvolver uma arma biológica que afete os russos, mas permaneça inofensiva para os ocidentais, disse Korotchenko.
Para isso, os EUA precisam coletar biomateriais e amostras genéticas de vários grupos étnicos que vivem na Rússia.
"[Spector] ajudou os ramos biológicos militares do Pentágono a coletar e transferir amostras relevantes com o objetivo de identificar possíveis vulnerabilidades no código genético de determinadas categorias da população russa", explicou Korotchenko.
Os serviços de contrainteligência russos estão cientes das atividades de pesquisa biológica do Pentágono na Rússia e as estão ativamente impedindo, observou o especialista.
O tenente-general Igor Kirillov, chefe das Tropas de Defesa Radiológica, Química e Biológica das Forças Armadas da Rússia, já havia exposto o sofisticado programa de armas biológicas do Pentágono operando na Ucrânia.
Em agosto, Kirillov revelou que, antes de 2022, os EUA haviam obtido até 16 mil amostras biológicas da Ucrânia com o objetivo de desenvolver vírus e bactérias perigosos para os ucranianos e russos étnicos.
O general Kirillov foi assassinado em um atentado a bomba no dia 17 de dezembro. Investigadores russos afirmaram que o ataque terrorista foi realizado por ordens dos serviços especiais ucranianos.
O Ministério da Defesa russo relata que as autoridades estadunidenses planejam criar, dentro de um ou dois anos, um centro para diagnóstico de doenças, testes de produtos médicos, estudo de patógenos perigosos e mecanismos de suas mutações, além do desenvolvimento e teste de vacinas modernas.
Para tal, os EUA já alocam de US$ 5 a US$ 10 milhões (R$ 40 a R$ 62 milhões) e podem expandir o financiamento até US$ 20 milhões (R$ 124 milhões).
De acordo com os dados do ministério, Washington criou um sistema de controle para gerenciar riscos biológicos em outros países. Ele foi testado com sucesso na Ucrânia e na Geórgia e agora está sendo usado ativamente no continente africano.
O sistema tem como objetivos: Obtenção de patógenos em áreas endêmicas e focos naturais; controle e gerenciamento da situação biológica para seu próprio benefício; análise da situação epidêmica ao longo das fronteiras dos adversários geopolíticos nas áreas planejadas para implantação de contingentes militares.
Mais lidas
-
1PERFIL | JUSTIÇA
Quem é a juíza Elizabeth Machado Louro, responsável pelo julgamento do Caso Henry Borel
-
2ATAQUE NA PRAIA DE PIEDADE
Menino de 11 anos é atacado por tubarão e passa por cirurgia em Pernambuco
-
3ACIDENTE INDUSTRIAL
Fábrica de fogos de artifício pega fogo e causa explosões em Malta
-
4TÊNIS BRASILEIRO FAZ HISTÓRIA
João Fonseca quebra jejum de mais de 20 anos ao chegar às quartas de final de Roland Garros
-
5CASO HENRY BOREL
Atual mulher de Jairinho depõe no julgamento e minimiza relatos de violência: 'Defeito dele era a infidelidade'


